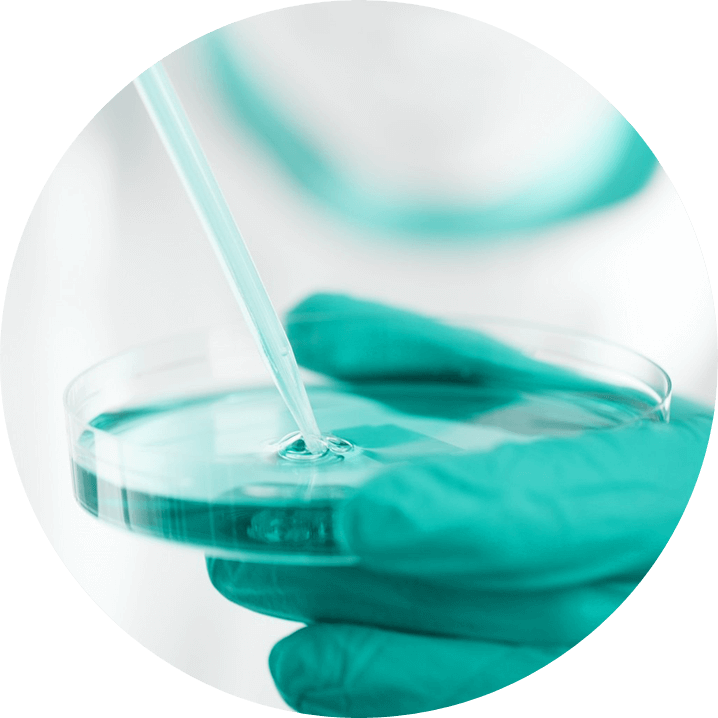

We all know and experience that our body cannot produce all the building blocks by itself, so we need to take in, through our diet, many substances that no longer require further modification. These include certain amino acids and vitamins. However, there are many metabolites circulating in our body that we cannot produce but are needed, and which were not taken in with our food. How is this possible? How are substances that we are not able to generate produced in us?
The answer lies in the microorganisms that live with us, on us, in us, in a mutually beneficial relationship, symbiosis. These microorganisms can be viruses, bacteria, and fungi – collectively known as the microbiome.
MICROBIOME DO?
The microbiome forms a living layer on our skin and inside our body, from the mouth to the colon. This means that we share our body with countless microorganisms of different species (150-500). But the most important ones are the bacteria that live in our gut.
Many of us have a negative approach to the word bacterium, even though only a very small proportion of bacteria are pathogenic; most of them are neutral or even beneficial for us.
The number of microorganisms in our gut is close to the number of cells in our body, but in terms of genes, there are about 100 to 1000 microbial genes for every human gene. It is already well known how important this gut flora is in maintaining our health. Our gut flora produces hundreds of thousands of different metabolites our body needs to carry out many functions, and it often regulates vital processes.
MICROBIOME AFFECT?
Changes in the composition and diversity of the microbiome have been linked to a number of common autoimmune and other diseases such as allergies, obesity, gastrointestinal diseases, diabetes, rheumatoid arthritis, cardiovascular diseases, and even the development of colorectal cancer, according to recent research.
Gut flora can vary, and age, lifestyle, medication, and existing diseases all have an impact on it. Nutrition is also an important factor as the composition and amount of food the body needs support beneficial microbes and inhibit harmful ones, thereby reducing discomfort and improving quality of life.
A MICROBIOME TEST?
Microbiome testing is a microbial analysis service based on the sequencing of microbial DNA in a stool sample. Stool analysis provides a comprehensive picture of the microbial communities in the colon, including the relative percentage distribution of bacteria, the bacterial species associated with inflammation, and allows you to assess how balanced your protein and fibre intake is.
REQUEST THE TEST?
Ask for our test if you are overweight, too thin, on a special diet, on antibiotics, or if you feel discomfort.
The microbiome test answers the following questions:
- What bacteria are found in your gut?
- Are there probiotic bacteria in your bacterial community?
- Does the bacterial community in your gut indicate any inflammation?
- Do you need to change your diet?
- How do supplements affect your gut microbiome?
- Are you eating enough fibre?
- Are you eating the right type of fibre?
- Are you eating too much fat and protein?
For further details and to order our test, please contact us at kapcsolat@mikrobiomvizsgalatok.hu.
Our laboratory is not a traditional microbiology laboratory in which bacteria are studied by culturing them on different media and visualizing them under microscopes. The disadvantage of this traditional testing is that in many cases bacteria are unable to survive outside the body or are present in such small numbers that they are overgrown by other bacterial species in culture tests. However, as a result of our special sample preservation process, the genetic material of bacteria is preserved and is detectable using Next-Generation Sequencing technology. This technique allows us to identify the genetic prints of all bacteria in the sample. This method is suitable for testing bacterial communities from living waters, food, or any other sample and represents the currently available state-of-the-art technology.